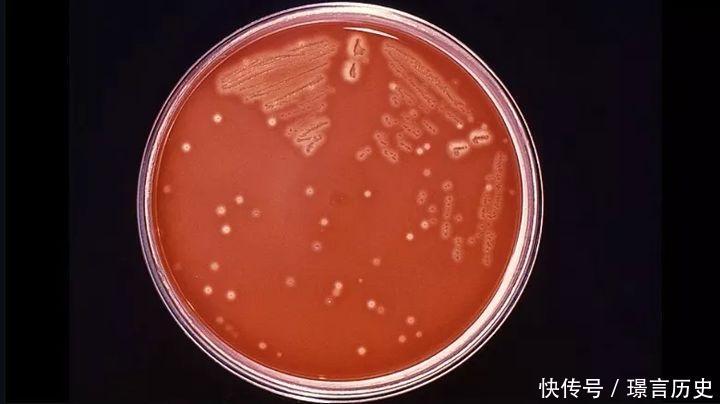

2016年,广州市海珠区一名75岁黎姓老人,在杀螃蟹时不慎右手虎口被蟹钳钳伤,因为伤口并不大,起初也没有引起老人的注意,因此他也没有对伤口做相应的处理。而后,黎伯的身体状况逐渐恶化,不但手背发红肿胀且发黑,他还不断腹泻、腹痛,在这种情况下,黎伯来到了医院急诊,刚进医院就已经休克,最终,不幸去世。

2019年,浙江萧山一位60多岁的王大伯在菜市场买了沼虾,回家处理时好像刺了一下手指,王大伯并没有在意,谁知道王大伯突然开始发热,很快陷入了昏迷,送来医院的时候已经神智不清,在短短3天的时间里,他的右腿上出现大量水泡,肌肉组织迅速坏死,最终抢救无效去世。

为什么仅仅被虾、蟹刺了一下,就会遭遇如此的悲剧,这不是虾蟹的原因,而是一些虾蟹含有一种恐怖细菌——食肉菌,食肉菌并不是单一一种细菌,而是引发坏死性筋膜炎、肌肉组织损坏的一类细菌的总称。大部分人为链球菌感染,还有克雷伯氏菌、梭状芽孢杆菌、大肠杆菌、金黄色葡萄球菌、嗜水气单胞菌和海洋创伤弧菌等,多数情况下为需氧菌和厌氧菌混合感染。
食肉菌是什么
食肉菌顾名思义,食肉菌会从人体内部将人“吃掉”,“吃掉”是一个形容词,当人体被食肉菌感染后,多种细菌侵入皮下组织和筋膜,需氧细菌首先消耗组织中的氧气,同时细菌分泌的酶将组织中的过氧化氢分解,使组织缺氧,创造出了适合厌氧菌生存的环境。
由于细菌的大量繁殖和毒素的作用,可以侵蚀肌肉和身体组织,溶解、破坏人体的脂肪、淋巴管、筋膜等结缔组织,并且使感染迅速沿着皮下间隙向周围扩散,因为体内组织被啃噬,感染者皮肤的伤口会越来越痛,体温会越来越高,因为肌肉和身体组织受到破坏。除此之外,食肉菌还可以在小血管内形成血栓,影响组织的血运,从而影响血液循环,进一步使身体组织坏死。

它们通常是通过伤口进入人体内,这种细菌在入侵身体后不到24小时便夺去一个人的生命。而且即使保住了生命,也是会有后遗症的,因为需要移除被食肉菌啃噬的组织,更甚者需要截肢,还需要植皮修复大面积的伤口。
根据2015年的数据统计,食肉菌感染者的死亡率高达50%。即使采用高质量的治疗,死亡率也只能控制在25%~35%之间。
这是因为早期食肉菌感染者的病症具有极强的迷惑性,约75%的患者都不能在早期发现,或者是被误诊了。同时,食肉菌的攻击手段也让人难以抵挡。就算展开快速积极的治疗,也不好治。

很多时候,医生更是只能看着食肉菌将一个人“啃食殆尽”,比如英国著名经济学家戴维·沃尔顿,遭食肉菌入侵,医生只能眼睁睁看着食肉菌在他们面前扩散,从沃尔顿的大腿一直蔓延到胸腔和肩头。这种细菌在入侵沃尔顿身体后不到24小时便夺去了他的生命。
感染食肉菌后,身体会恶臭
因为体内的脂肪、淋巴管等结缔组织被溶解,组织、器官逐渐坏死并液化,从表皮不断增大的破损面积渗出破溃物质,所以在短时间内,人会亲眼看着自己腐烂,并且散发出像被侵蚀肉体般的恶臭。
我们可以从皮肤的变化看到这样的过程,食肉菌刚感染人体的时候,感染局部皮肤出现红斑并迅速向周围扩散, 随着食肉菌不断地繁殖,数量的增加,对人体组织的侵蚀不断深化, 数小时到数天内, 红斑逐渐变成暗黑色或暗紫色, 多个斑片融合形成大片皮肤坏疽, 这就意味着皮下组织大量坏死。 此时皮肤出现特征性的紫色大水疱伴有剧痛, 这则说明了我们的筋膜组织已经被食肉菌破坏。既然都坏死了,肯定就会发臭嘛。
2018年,俄罗斯著名音乐人苏其林乘坐着一架从荷兰飞往西班牙大加那利岛(Gran Canaria) 的泛航航空(Transavia) 波音737客机,在抵达目的地前临时改变航线,紧急转向到葡萄牙迫降,
之所以会紧急迫降,理由是许多乘客在飞行期间止不住呕吐、头晕,他们不是晕机,而是飞机中散发着难闻的恶臭,恶臭正是从苏其林身上发出的。
另外许多乘客也纷纷投诉苏其林身上实在太臭了,像是几个星期没洗澡一样。于是机长最终决定迫降,并把苏其林请下飞机。苏其林也只好接受这个安排。

苏其林不是没有洗澡,而是患上了食肉菌。他的皮下组织和筋膜组织已经被食肉菌啃食坏死,导致身体发出可怕的恶臭。
在下飞机后,他被送往医院救治,但是他最终还是不治身亡了。而这位摇滚音乐人在人生中最后阶段,竟然是以这种形式戏谑地逼停了一架飞机。
如何避免感染食肉菌
大家一定要小心谨慎处理海产品。如果不小心被买回来的海鲜弄伤了手,记住要马上用消毒药水清洁,如出现皮肤红肿、疼痛、发热等感染表现,应及时到医院就诊。
皮肤有破溃或者刚文身后,避免游泳尤其是下海游泳,避免接触海产品,避免进行耕作等户外活动。没有错,田地里也可能感染食肉菌,就比如广州有一名70岁阿伯,在田间耕种的时候就中了招,他一开始没有理会。结果第二天食肉菌就已经蚕食了他的臀部、腹壁等处,经过治疗,阿伯这才保住了性命。

如果实在想去游泳,可以用防水绷带包扎伤口再进行活动,最后,尽量不少食用生的或未煮熟的贝类。
友情提示
本站部分转载文章,皆来自互联网,仅供参考及分享,并不用于任何商业用途;版权归原作者所有,如涉及作品内容、版权和其他问题,请与本网联系,我们将在第一时间删除内容!
联系邮箱:1042463605@qq.com